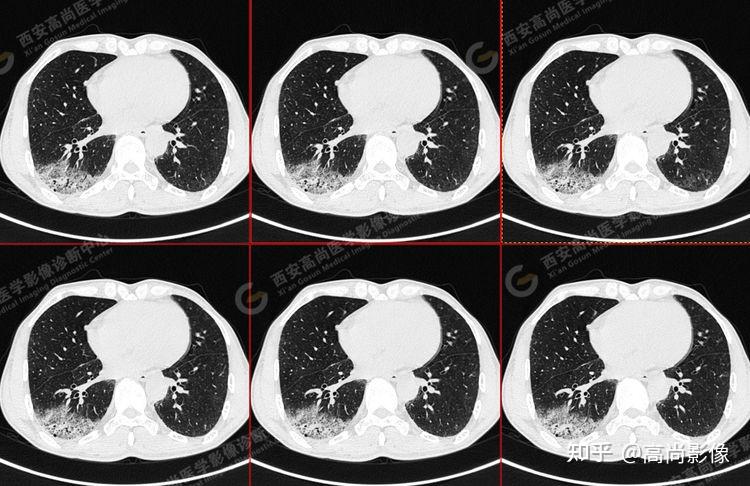
pet/ct病例—肺粘液腺癌,历经3年余终确诊【西安高尚医学影像诊断中心
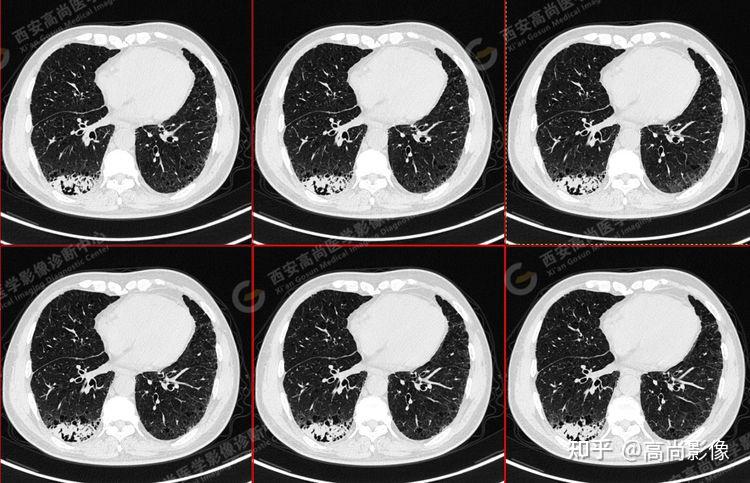
pet/ct病例—肺粘液腺癌,历经3年余终确诊【西安高尚医学影像诊断中心
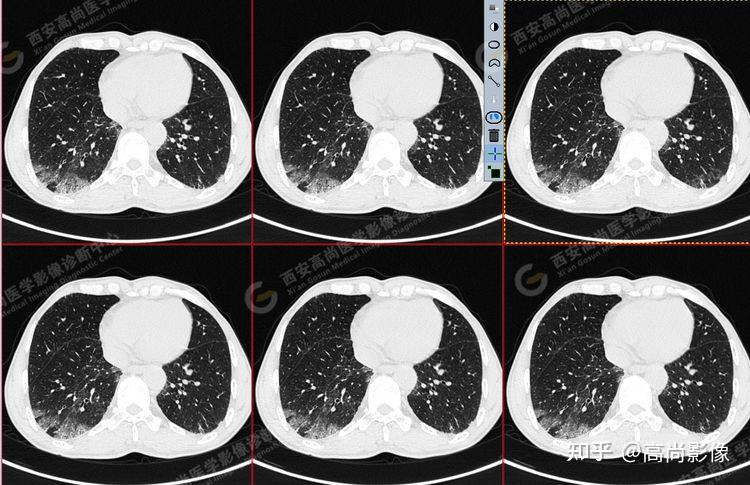
pet/ct病例—肺粘液腺癌,历经3年余终确诊【西安高尚医学影像诊断中心

肺粘液腺癌

肺粘液腺癌,已生存50个月
图片尺寸750x613
肺粘液腺癌,是一种会伪装成"肺炎"和"良性结节"的癌细胞!
图片尺寸375x409
女,63岁,肺粘液腺癌一例
图片尺寸677x651
女,63岁,肺粘液腺癌一例
图片尺寸676x710
肺粘液腺癌,是一种会伪装成"肺炎"和"良性结节"的癌细胞!
图片尺寸1242x932
恶之花黏液腺癌一例30岁年青男性的10mm肺实性结节
图片尺寸2639x3000
女,63岁,肺粘液腺癌一例
图片尺寸677x522
女,63岁,肺粘液腺癌一例
图片尺寸675x490
pet/ct病例—肺粘液腺癌,历经3年余终确诊【西安高尚医学影像诊断中心
图片尺寸750x486
再解肺粘液腺癌
图片尺寸508x367
肺粘液腺癌,已生存50个月
图片尺寸750x623
pet/ct病例—肺粘液腺癌,历经3年余终确诊【西安高尚医学影像诊断中心
图片尺寸750x483
女,63岁,肺粘液腺癌一例
图片尺寸676x475
女,63岁,肺粘液腺癌一例
图片尺寸676x440
pet/ct病例—肺粘液腺癌,历经3年余终确诊【西安高尚医学影像诊断中心
图片尺寸750x485
pet/ct病例—肺粘液腺癌,历经3年余终确诊【西安高尚医学影像诊断中心
图片尺寸750x485
肺粘液腺癌,胰腺转移一例
图片尺寸1044x960